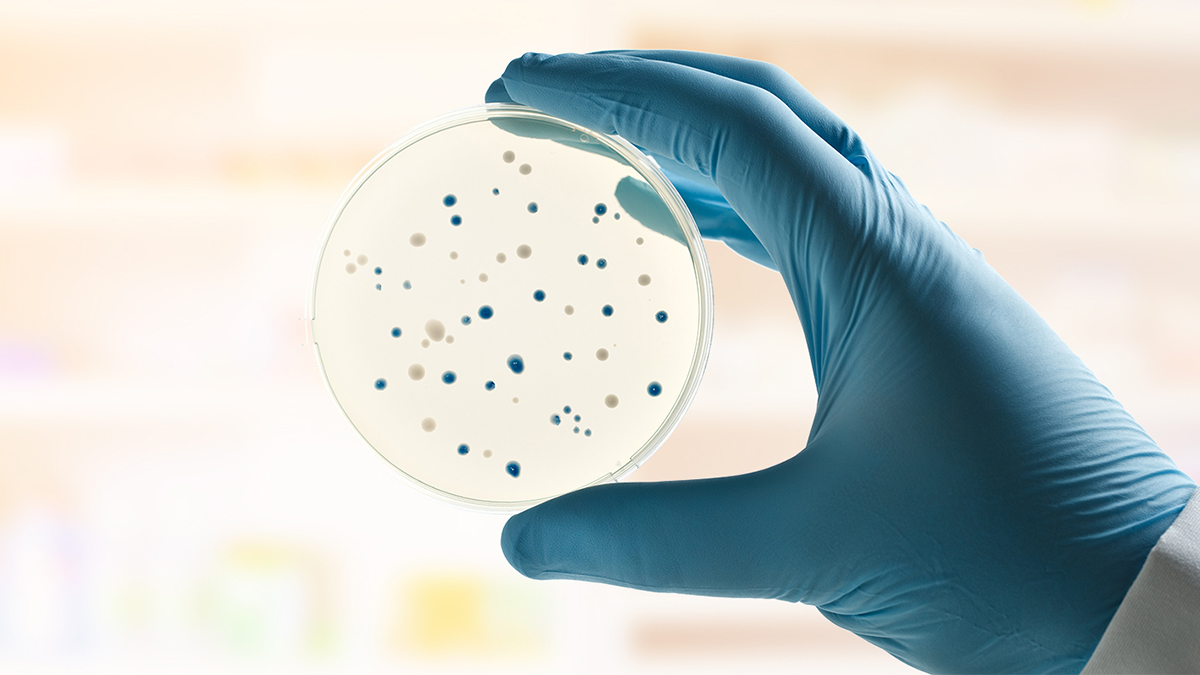

Beyond Use Dating: The North York General Hospital Experience

Compounding IV medications is an important core competency of pharmacy practice both in hospital and community settings. In September 2016 the Ontario College of Pharmacists adopted the NAPRA Model Standards for Pharmacy Compounding for both Non-hazardous and Hazardous Sterile Preparations. These documents have provided the standards and framework that pharmacies must follow in order to ensure the quality of products dispensed.
The standards are broken into three main areas: training, product preparation and quality assurance. The quality assurance component includes consideration of what beyond use dates (BUD) should be given to products.
As pharmacies try to provide efficient pharmacy services, there has been a move to have products in a ready to administer format rather than to compound just-in-time. This move has resulted in the need for pharmacies to have medications prepared in anticipation of an order or prescription. Prior to the introduction of these standards, many pharmacies only took the stability of the product into account when assigning beyond use dating. However, the NAPRA Model Standards for Pharmacy Compounding also takes the sterility of the product into consideration and therefore, in many instances, the length of time that products can be safely stored has decreased. This has become a significant challenge for pharmacies that tried to compound less frequently to increase efficiencies.
As North York General Hospital (NYGH) was implementing the new BUD standards, where the maximum BUD that can be applied to medium risk products is nine days refrigerated or 30 hours at controlled room temperature, it was recognized that these time periods are not always practical to meet patient needs. To extend BUD, end product sterility testing (EPST) must be conducted. The following is a step-by-step description of how NYGH implemented end product sterility testing to extend BUDs.
It is important to note that only facilities that have met the standards and reviewed the College’s Extending the Beyond-Use Dates for Sterile Preparations Guideline should attempt to extend BUDs.
Step 1: CIVA Product Analysis
EPST could be costly from both a materials and staffing perspective if all products undergo testing. Therefore, it makes sense that not all products with long chemical stability should undergo EPST. To determine the short-list of products to consider, each organization needs to define the criteria under which EPST is appropriate. The following are the list of criteria NYGH Pharmacy used to determine products that need to have extended BUD:
- Currently batched: If the product is not batched already then EPST does not need to be done.
- Floor stock products: These products often have unpredictable usage patterns and therefore a limitation of nine days may result in significant wastage.
- Inventory turnover rate for each product: If a product is a fast mover and is always used up in less than nine days then EPST would not be needed.
- Cost analysis of conducting EPST vs. more frequent compounding: Products that have minimal production costs, such as tubing for pumps, may not be very costly to compound more regularly. Staffing patterns for the cleanroom may also play a role in this requirement. If staff are not available on a regular basis to compound, then longer shelf-life is needed for products.
Once NYGH completed this analysis, only nine products were appropriate for EPST.
Step 2: Select an EPST Product
There are various EPST products on the market and each organization will need to conduct their own review to determine which product they want to use. NYGH focused on those products that were simple to use and did not require a significant capital investment. When choosing a product, it is important to consider the cost of the test relative to the cost of the product being tested. If the test is more expensive than the potential wastage, it may not be worthwhile to do the test.
Step 3: Develop Policy and Procedure for EPST
A policy and procedure document was developed, incorporating standards from USP 71 Sterility Tests. The document specified the number of samples required for sterility testing based on batch size, the incubation temperature (with acceptable deviations), the duration of incubation, when a batch could be released for use, an outline of investigation procedures to follow in case of a positive EPST, and the quarantine/recall procedure.
Step 4: Education/Training of Staff
Before implementing EPST, pharmacy staff needed to be educated on the policies and procedures, how to perform the EPST, how to read/interpret the sterility testing sample, the documentation process, and what to do in case of a positive EPST result. For successful implementation, it is important to look at how to incorporate these activities into existing workflow.
Step 5: “Quarantine” and Release of Product
To ensure products undergoing EPST are not used prior to passing the EPST, it is important to designate a “quarantine” location for these products. At NYGH this was accomplished by using a different coloured bin and designating a specific area to store quarantined room temperature and refrigerated temperature products. In addition, laminated quarantine cards were used to help identify the earliest date quarantined products could be released if EPST results were negative.
Step 6: Record Keeping and Continuous Quality Improvement (CQI)
Proper documentation of each EPST performed, including the results, must be available in a readily retrievable format. At NYGH, all EPST and corresponding compounding worksheets are scanned to facilitate easy retrieval.
With implementation of any new process, an important step is to perform a review of the new processes regularly, and after any changes to the process, to continually evaluate it for potential areas for improvement to ensure patient safety, reproducibility and efficiency.
Conclusion
End product stability testing may seem daunting to implement at first glance, but the experience at NYGH showed that in reality only a handful of sterile products require EPST. The majority of the sterile compounds did not need extended BUD. While it took effort and resources to implement, with a particular focus on staff training, the actual additional workload has not been significant.